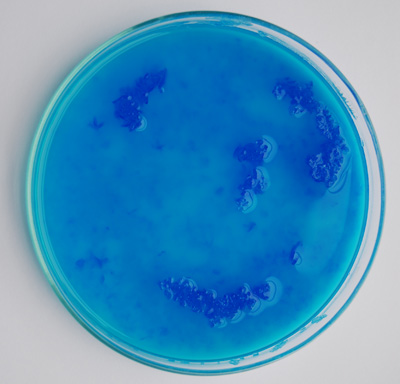

Det er spændende at se dannelsen af de smukke, blå krystaller.
Blå krystaller af kobbersulfat

Salte danner krystaller, og en af de flotteste er blåsten. I kemien kalder vi det for kobbersulfat og bruger formlen er CuSO4.
Formål
At påvise dannelsen af saltkrystaller
At arbejde med en mættet saltopløsning
Materialer
Kobbersulfat Petriskål 500ml bægerglas Træpind, glødepind Sytråd
Teori
Vand kan opløse salte, og når der er rigtig meget salt i, bliver blandingen overmættet.
Der dannes bundfald og saltkrystaller.
En saltopløsning kan blive overmættet ved at vandet fordamper, eller hvis den afkøles.
Vandet fordamper nemmest, når der er en stor overflade, f.eks. en flad skål.
Krystaller dannes nemmest uden på et krystal, der er dannet i forvejen. Vi kalder det et podekrystal.
De første krystaller er dannet.
De første krystaller er dannet.
Forsøg 1: Lav et podekrystal
· Kog ca. 2 dl vand og hæld 100 ml i et bægerglas
· Tilsæt 50 g kobbersulfat og omrør til alt er opløst i det varme vand
· Hæld opløsningen op i en stor petriskål
· Vent nogle timer, evt. til næste dag
· Udvælg et pænt podekrystal og bind en snor i det
· Brug podekrystallet i forsøg nr. 2

Podekrystallet hænger i en sytråd og vokser sig større, time for time.
Forsøg 2: Dannelsen af flotte, blå krystaller
· Kog ca. ½ l vand og hæld 300 ml i et bægerglas
· Tilsæt 150 g kobbersulfat og omrør til alt er opløst i det varme vand
· Lad opløsningen stå og køle af, så den er mellem stuetemperatur og håndvarm
· Anbring podekrystallen midt i væsken.
Lad den hænge i en sytråd fra en lille pind, som ligger på tvær hen over bægerglasset
· Anbring bægerglasset et sted, hvor der ikke er rystelser
· Iagttag krystallet efter nogle timer og de næste dage
